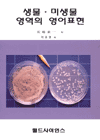
생물. <span class="sponge-point-color">미생물</span> 영역의 영어표현

731 항목 일치
미생물 사냥꾼 : 미생물 연구에 일생을 바친 13명의 위대한 영웅들
5
| 청구기호 | 579.0922-K94m이 | 저자 | Kruif, Paul De | 출판사 | 반니 | 출판년 | 2017 |
|---|
(보이지 않는 지구의 주인) 미생물 - [전자자료] : 세상을 움직이는 신비한 미생물의 세계를 탐험하다
8
| 청구기호 | 전자도서-EB | 저자 | 오태광 | 출판사 | 양문 | 출판년 | 2008 |
|---|






![(보이지 않는 지구의 주인) <span class="sponge-point-color">미생물</span> - [전자자료] : 세상을 움직이는 신비한 <span class="sponge-point-color">미생물</span>의 세계를 탐험하다](https://bookthumb-phinf.pstatic.net/cover/047/028/04702867.jpg)